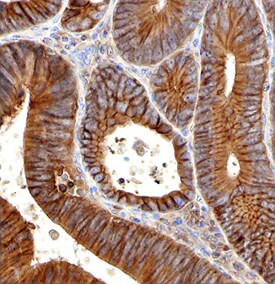
PLXNB2 Antibody in Immunohistochemistry (Paraffin) (IHC (P))

Search
Invitrogen
PLXNB2 Polyclonal Antibody
{{$productOrderCtrl.translations['antibody.pdp.commerceCard.promotion.promotions']}}
{{$productOrderCtrl.translations['antibody.pdp.commerceCard.promotion.viewpromo']}}
{{$productOrderCtrl.translations['antibody.pdp.commerceCard.promotion.promocode']}}: {{promo.promoCode}} {{promo.promoTitle}} {{promo.promoDescription}}. {{$productOrderCtrl.translations['antibody.pdp.commerceCard.promotion.learnmore']}}
图: 1 / 4
PLXNB2 Antibody (PA5-47721) in IHC (P)




产品信息
PA5-47721
种属反应
宿主/亚型
分类
类型
抗原
偶联物
形式
浓度
规格
纯化类型
保存液
内含物
保存条件
运输条件
RRID
产品详细信息
In direct ELISAs, less than 1% cross-reactivity with recombinant mouse (rm) Plexin A1, rmPlexin A2, recombinant human (rh) Plexin A4, rhPlexin B1, rhPlexin B3, rhPlexin C1 and rhPlexin D1 is observed.
Reconstitute at 0.2 mg/mL in sterile PBS.
靶标信息
Plexin-B2 is a member of the Semaphorin receptor family. The semaphorin family consists of membrane and secreted proteins involved in attraction and repulsion of neuronal guidance cues. Plexin-B1 is a transmembrane protein that can be cleaved converting the single chain precursor into a heterodimeric receptor. It has been shown to bind Sema4D/CD100 and is involved in axon development in mouse embryos. Sema4D also plays a role in the immune system interacting with CD72. Plexin-B2's possible role in the immune system has not been characterized.
仅用于科研。不用于诊断过程。未经明确授权不得转售。
篇参考文献 (0)
生物信息学
蛋白别名: ferroptosis-associated lncRNA; KIAA0315; MM1; MM1KIAA0315dJ402G11.3; Plexin-B2
基因别名: dJ402G11.3; KIAA0315; lncFAL; MM1; Nbla00445; PLEXB2; PLXNB2
UniProt ID: (Human) O15031
Entrez Gene ID: (Human) 23654